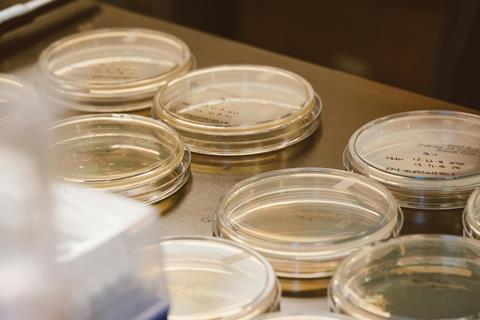

A brief research report found that incidence of a specific antibiotic-resistant bacteria increased 69% between 2019 and 2023.
The report described trends in incidence of carbapenemase-producing carbapenem-resistant Enterobacterales (CRE) (CP-CRE) clinical isolates reported to the Antimicrobial Resistance Laboratory Network of the Centers for Disease Control and Prevention (CDC) during the timeframe.
The findings showed that in 29 states with mandated CRE isolate reporting, incidence of CP-CRE cultures surged between 2019 and 2023, primarily due to NDM (New Delhi metallo-b-lactamase). The findings indicate that the changing epidemiology of CP-CRE poses significant challenges for managing CRE infection. The study is published in Annals of Internal Medicine.
Carbapenemases drive the spread of CRE. The type of carbapenemase affects treatment options, as fewer agents are active against CRE with NDM and other metallo-b-lactamases compared to KPC (Klebsiella pneumoniae carbapenemase).
The findings
Researchers from the National Center for Emerging and Zoonotic Infectious Diseases at the CDC developed an open cohort of 29 states with mandated CRE isolate submission. They estimated annual aggregate and state-specific CP-CRE incidence rates overall and by carbapenemase.
The researchers found that the annual unadjusted incidence of CRE increased by 18% (IRR, 1.18 [95% CI, 1.14–1.22]) from 2019 to 2023, and when adjusted for age, the incidence of CP-CRE increased by 69% (IRR, 1.69 [CI, 1.61–1.78]). The age-adjusted incidence of NDM-CRE increased 461% (IRR, 5.61 [CI, 4.96–6.36]). KPC-CRE incidence decreased from 2019 to 2020 and then rose.
By 2023, NDM-CRE incidence was comparable to KPC-CRE, and NDM became the most common carbapenemase in E coli. The researchers note that understanding local CRE epidemiology and integrating mechanism testing into laboratory workflows may help ensure patients receive timely, appropriate therapy.
No comments yet